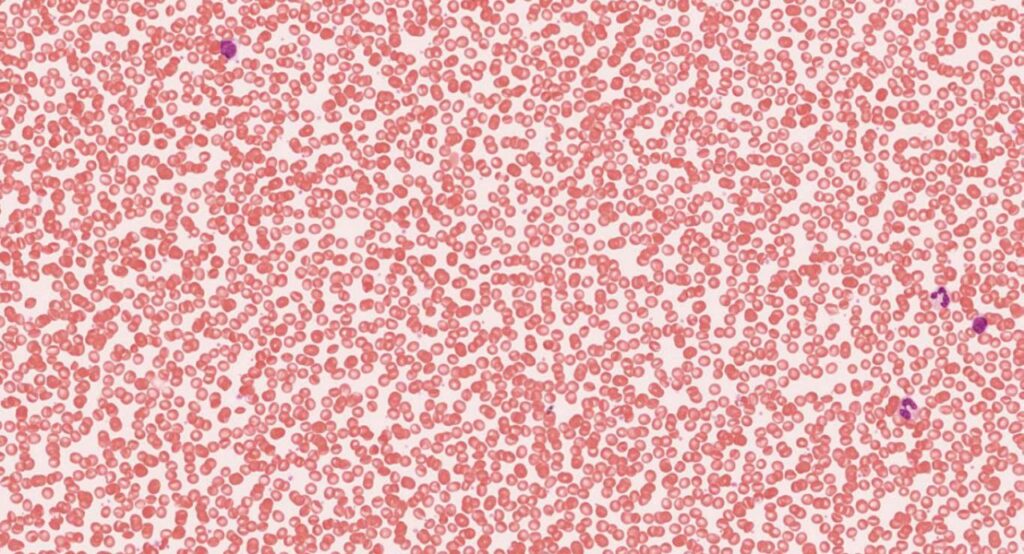
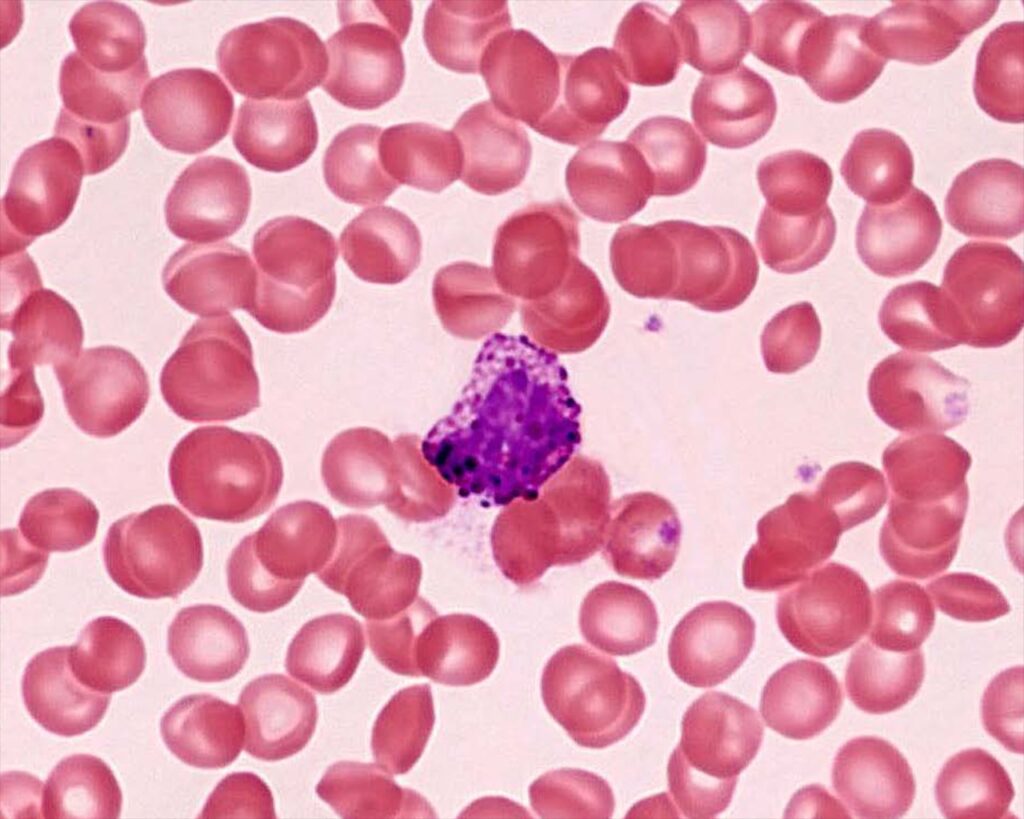

Диагностика рака
Ранняя диагностика спасает жизни и позволяет организовать правильное и своевременное лечение.
Рак — одна из самых актуальных проблем современной медицины. На ранних стадиях злокачественные заболевания часто протекают бессимптомно; поэтому лишь небольшое количество пациентов может диагностировать их на основании клинических признаков.
В прошлом только в развитых странах рак был одной из основных причин смерти. Однако в последние десятилетия в развивающихся странах из-за снижения числа инфекционных заболеваний и заболеваний, связанных с недоеданием, рак быстро стал ведущей причиной смерти.

13% в развитых
странах
Эпидемиологические данные показывают, что на смерть от рака приходится на 13% из 22 миллионов смертей в год в развитых.

20% в развивающихся странах
20% смертей из 12 миллионов в развивающихся странах.

33%
За последние 10 лет заболеваемость раком увеличилась на 33%.
Различные виды рака являются ведущей причиной смерти во всем мире. На лечение рака тратятся миллиарды долларов.
По оценкам Всемирной организации здравоохранения, в следующие 20 лет количество случаев рака увеличится на 70%.
В связи с этим чрезвычайно важны все аспекты рака (заболеваемость, смертность, факторы риска, борьба с раком, ранняя диагностика, профилактика).

Semidal
Semidal современная компания, имеет технологию которая помогает обнаружить онкозаболевания на ранних стадиях, а также позволяет сопровождать лечение для определения его действенности и эффективности.
Как происходит диагностика?
Как биоматериал используется капиллярная и венозная кровь (без применения инвазивных методов, которые сами по себе могут нанести вред пациенту). Процедура отбора крови обычна и привычна для любого человека хотя бы один раз посетившего лабораторию.
Задействуем разработанный нами медицинский комплекс в решении задачи ранней диагностики рака мы применяем технологию компьютерного зрения в сочетании с искусственным интеллектом.


На протяжении нескольких лет проводились исследования образцов крови на основе инновационного подхода к методологии и технологии. Результатом исследований стала запатентованная технология определения онко-статуса человека и медицинский комплекс Semidal с ИИ для диагностических лабораторий.
Достигнута точность выше 90%.
Процесс диагностики

Приняла активное участие в благотворительной программе и получили бесплатную диагностику от компании. Довольна обширным спектром анализов от мед. центра.
Светлана М.

Добрый день, благодарю всех организаторов. Всё прошло быстро и легко.
Виталий О.

Отлично что в наших краях появилась ранняя диагностика, это очень важно.
Иван К.
Let’s work together on your
next web project
Lorem ipsum dolor sit amet, consectetur adipiscing elit. Ut elit tellus, luctus
nec ullamcorper mattis, pulvinar dapibus leo.